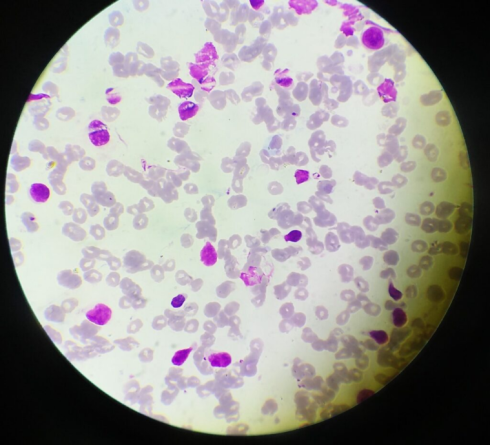
رنگ گیمسا

ابزار و وسایل آزمایشگاهی شامل، محلول ها کیت ها
رنگ گیمسا (Giemsa): اصول، پروسه آمادهسازی و استفاده، نتایج و تفسیر
مقدمه رنگ گیمسا
رنگ گیمسا از نام یک دانشمند شیمیدان آلمانی اقتباس شد که برای نشان دادن وجود انگل در مالاریا، از ترکیبی از شناساگرها استفاده کرد.
این رنگ متعلق به گروهی از رنگها به نام رنگهای رومانوفسکی (Romanowsky) میباشد. رنگهای گیمسا رنگهای خنثی هستند که ترکیب آنها متشکل از اکسید متیلن بلو (oxidized methylene blue)، آزور (Azure) و ائوزین Y (Eosin Y) میباشد و روی یک لام که با هوا خشک شده و پس از اینکه با متانول تثبیت شده، به کار میروند. رنگهای رومانوفسکی در افتراق سلولها، بررسیهای پاتولوژیک نمونههایی مانند فیلمهای خون (Blood film) و مغز استخوان و نشان دادن انگلهایی مانند مالاریا استفاده میشوند. چهار نوع رنگ رومانوسسکی وجود دارد:
- رنگ Giemsa
- رنگ Jenner
- رنگ Wright
- رنگ May-Grunwald
- رنگ Leishman
اهداف رنگآمیزی با رنگ گیمسا
- برای تهیه دقیق محلول ذخیره رنگ گیمسا (Giemsa Stain Stock Solution)
- برای رنگآمیزی و شناسایی سلولهای خونی
- برای افتراق هسته سلولهای خونی از سیتوپلاسم
اصول
رنگآمیزی گیمسا یک تکنیک رنگآمیزی استاندارد است که هم برای اسمیرهای نازک و هم ضخیم در آزمایش خون از نظر انگلهای مالاریا، چکاپ معمول برای سایر انگلهای خونی و افتراق مورفولوژیکی هسته و سیتوپلاسم اریتروسیتها (Erythrocyte)، لکوسیتها (Leucocyte) و پلاکتها و انگلها، استفاده میشود.
مانند انواع دیگر رنگهای رومانوفسکی، این رنگ از هر دو رنگ اسیدی و بازی (در رابطه با میل اسیدیته و بازی سلولهای خونی) تشکیل شده است. ترکیب آزور و متیلن بلو، یک رنگ پایهای است که به هسته اسید متصل میشود و رنگ آبی-بنفش تولید میکند. ائوزین یک رنگ اسیدی است که جذب سیتوپلاسم و گرانولهای سیتوپلاسمی که خاصیت قلیایی دارند، شده و رنگ قرمز تولید میکنند. رنگ باید در آب با pH 6.8 تا 7.2 بافر شود تا رنگها سریعتر به مواد ساده بچسبند.
به طور کلاسیک، رنگ گیمسا یک رنگ افتراقی است که از ترکیبی از شناساگرها (آزور ، متیلن بلو و ائوزین) ساخته شده است و به طور گسترده در سیتوژنتیک (Cytogenetics) و هیستوپاتولوژی (Histopathology) برای تشخیص موارد زیر استفاده میشود:
- مالاریا، اسپیروکتها (Spirochete) و سایر انگلهای خونی
- اجسام انکلوزیونی کلامیدیا تراکوماتیس (Chlamydia trachomatis inclusion bodies)
- باکتریهای بورليا (Borrelia spp)
- باکتری یرسینیا پستیس (Yersinia pestis)
- هیستوپلاسما (Histoplasma)
- کیستهای پنوموسیستیس جیرووسی (Pneumocystis jiroveci)
شناساگرهای مورد استفاده
- متانول
- پودر گیمسا
- گلیسرین
- آب (بافر)

پروسه آمادهسازی و استفاده
تهیه محلول ذخیره رنگ گیمسا به میزان 500 میلیلیتر
- به 250 میلیلیتر متانول، 3.8 گرم پودر گیمسا اضافه کرده و حل کنید.
- محلول را تا 60 درجه سانتیگراد گرم کنید.
- سپس 250 میلیلیتر گلیسیرین را به آرامی به محلول اضافه کنید.
- محلول را فیلتر کنید و بگذارید حدود 1 تا2 ماه قبل از استفاده بماند.
تهیه محلول کاری جهت استفاده
- 10 میلیلیتر محلول ذخیره را به 80 میلیلیتر آب مقطر و 10 میلیلیتر متانول اضافه کنید.
روش رنگآمیزی 1: رنگآمیزی لایه نازک
- روی یک لام شیشهای میکروسکوپی خشک و تمیز، یک لایه نازک از نمونه (خون) ایجاد کنید و بگذارید تا در هوا خشک شود.
- اسمیر را (2 تا 3 بار) در متانول خالص برای تثبیت آن فرو ببرید و بگذارید برای 30 ثانیه در هوا مانده تا خشک شود.
- لام را در محلول رنگ 5 درصد گیمسا به مدت 20 تا 30 دقیقه قرار دهید.
- با آب شیر بشویید و بگذارید خشک شود.
توجه: در مواقع اضطراری لام را در محلول رنگ گیمسا به مدت 5 تا 10 دقیقه قرار دهید.
روش رنگآمیزی 2: رنگآمیزی لایه ضخیم
- یک اسمیر ضخیم از خون را روی لام اضافه کنید و به مدت 1 ساعت روی یک سبد رنگآمیزی در معرض هوا قرار داده و خشک کنید.
- اسمیر خون ضخیم را در رنگ رقیق شده گیمسا (که با استفاده از 1 میلیلیتر محلول ذخیره و افزودن 49 میلیلیتر بافر فسفات یا آب مقطر تهیه شده است) فرو ببرید.
- اسمیر را با فرو بردن آن در آب بافرشده یا آب مقطر به مدت 3 تا 5 دقیقه بشویید.
- بگذارید تا اسمیر خشک شود.
نتایج
- سیتوپلاسم و گرانولهای سیتوپلاسمی سلولهای خونی به رنگ قرمز ظاهر میشوند در حالی که هسته به رنگ آبی-بنفش در میآید.
- گلبولهای قرمز به رنگ صورتی ظاهر میشوند.
- ائوزینوفیلها (Eosinophil) دارای هسته آبی-بنفش، سیتوپلاسم صورتی کم رنگ و گرانولهای نارنجی-قرمز خواهند شد.
- نوتروفیلها (Neutrophil) با هسته قرمز-بنفش و سیتوپلاسم صورتی ظاهر میشوند.
- بازوفیلها (Basophil)، هسته ارغوانی و گرانولهای مایل به آبی خواهند داشت.
- لنفوسیتها (Lymphocyte) دارای هسته آبی تیره و سیتوپلاسم آبی روشن هستند.
- مونوسیتها (Monocyte) دارای یک هسته بنفش و یک سیتوپلاسم صورتی خواهند بود.
- پلاکتها دارای گرانولهای بنفش رنگ خواهند بود.
تفسیر
ترکیب Azure و متیلن بلو، یک رنگ پایه بوده که به هسته اسید متصل میشود و رنگ آبی-بنفش تولید میکند. ائوزین یک رنگ اسیدی است که به سیتوپلاسم و گرانولهای سیتوپلاسمی که دارای خاصیت قلیایی هستند، جذب شده و رنگ قرمز-نارنجی تولید میکنند.

کاربردهای رنگ گیمسا
- رنگ گیمسا مخصوص گروههای فسفات DNA است و خود را به مناطقی از DNA که در آن مقادیر زیاد پیوند آدنین-تیمین (Adenine-Thymine) وجود دارد، میچسباند.
- از رنگ گیمسا در باندینگ گیمسا (G-banding)، برای رنگآمیزی کروموزومها استفاده میشود و اغلب برای ایجاد یک نمایش نموداری از کروموزومها (ایدئوگرام)، استفاده میشود.
- از آنجا که رنگ گیمسا یک رنگ افتراقی میباشد، میتوان از آن برای بررسی چسبندگی باکتریهای بیماریزا به سلولهای انسانی استفاده کرد و سلولهای انسانی را با رنگ بنفش از سلولهای باکتریایی با رنگ صورتی متمایز میکند.
- میتوان از آن برای تشخیص هیستوپاتولوژی مالاریا و برخی انگلهای خونی اسپیروکت و تکیاخته استفاده کرد.
- همچنین در رنگآمیزی بافت Wolbach، یعنی رنگآمیزی بافت خونساز و برای شناسایی باکتری و ریکتزیا (Rickettsia) استفاده میشود.
- رنگ گیمسا یک رنگ کلاسیک بلاد فیلم برای نمونههای اسمیر خون محیطی و مغز استخوان میباشد که در آن گلبولهای قرمز به رنگ صورتی، پلاکتها به رنگ صورتی کمرنگ، سیتوپلاسم لنفوسیت به رنگ آبی آسمانی، سیتوپلاسم مونوسیت به رنگ آبی کمرنگ، و کروماتین (Chromatin) هسته لکوسیت به رنگ ارغوانی درمیآیند.
- از رنگ گیمسا همچنین برای تصویرسازی کروموزومها، شناسایی ناهنجاریهای کروموزومی مانند جابجایی و بازآرایی استفاده میشود.
- رنگهای گیمسا، قارچ هیستوپلاسما (Histoplasma) و باکتری کلامیدیا را رنگ میکند و میتواند برای شناسایی ماست سلها (Mast cell) استفاده شود.
مزایا
این رنگ به راحتی در دسترس بوده و آمادهسازی، نگهداری و استفاده از آن آسان است.
محدودیتها
رنگ گیمسا باید کمی قبل از استفاده آماده شود.
جهت خرید و یا استعلام قیمت با ما تماس بگیرید یا در واتسپ پیام بزارید
مترجم: فاطمه فریادرس






سلام.ما کیت رنگ آمیزی گیمسا روز آزمون خریداری کردیم.خواستم بدونم رقیق سازی و زمان روی لام این چقدر هست
پروتوکل خود محصول را مطالعه بفرمایید
رنگ آماده گیمسا برای رنگ آمیزی لام موجود دارید؟
جهت استعلام قیمت با ما تماس بگیرید
درود
رنگ آمیزی سلولهای خونی رو چجوری انجام بوم؟ گیمسا فقط دارم